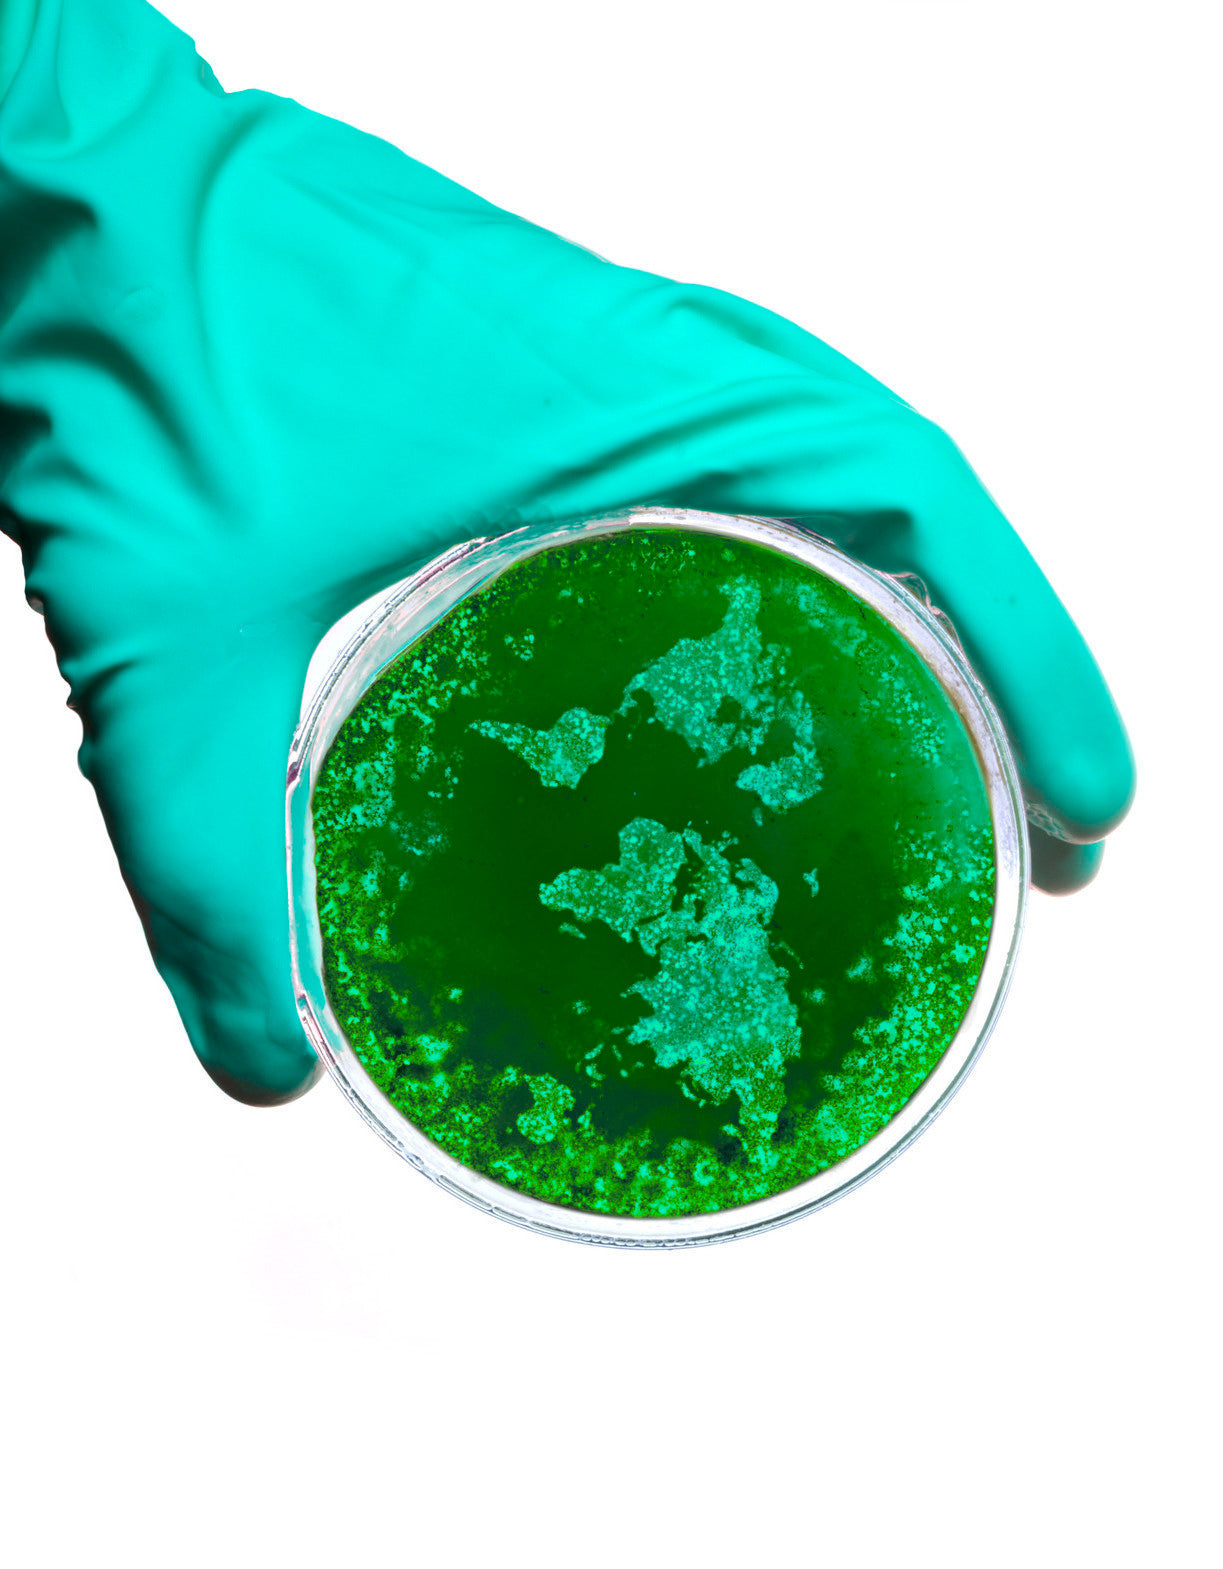

The Plague Within
The Plague Within
July 5, 2016
According to a good hadith related by Ahmad and al-Tabarani, the Messenger of God, may God’s peace and blessings be upon him, said, “You will never believe until you show mercy to one another.”
“All of us are merciful, O Messenger of God!” his companions responded.
The Prophet, God’s peace and blessings upon him, explained, “I’m not talking about one of you showing mercy to his friend; I’m talking about universal mercy—mercy towards everyone.”
For those Muslims and people of other faiths who lost loved ones in the recent tragedies in Baghdad two days ago, in Bangladesh last Friday, in Istanbul the day before that, in Lebanon earlier last week, and in Yemen and Orlando last month, I am deeply saddened and can only offer my prayers, even as I am painfully aware of my state of utter helplessness at what has befallen our global community. As I write this, I learned about yet another bombing outside our beloved Prophet’s mosque in Medina, as believers were about to break their fast yesterday, unjustly killing four innocent security guards. Fortunately, due to the blessings of the place, the sound of the explosion was thought to be the boom of the cannon used to announce the time has come to break the fast, so the people in the mosque were not frightened nor panicked. The Prophet, God’s peace and blessings upon him, said, “Whoever frightens the people of Medina has the damnation of God, the angels, and all of humanity.” Needless to say, the horror of these atrocities is compounded because they are being carried out—intentionally—in the blessed month of Ramadan.
A plague is upon us, and it has its vectors. Like the brain-eating amoebas that have struck the warm waters of the Southern states in America, a faith-eating plague has been spreading across the global Muslim community. This insidious disease has a source, and that source must be identified, so we can begin to inoculate our communities against it.
New versions of our ancient faith have sprung up and have infected the hearts and minds of countless young people across the globe. Imam Adel Al-Kalbani, who led prayers in the Haram of Mecca for several years, has publicly stated that these youth are the bitter harvest of teachings that have emanated from pulpits throughout the Arabian Peninsula, teachings that have permeated all corners of the world, teachings that focus on hatred, exclusivity, provincialism, and xenophobia. These teachings anathematize any Muslim who does not share their simple-minded, literalist, anti-metaphysical, primitive, and impoverished form of Islam, and they reject the immense body of Islamic scholarship from the luminaries of our tradition.
Due to a sophisticated network of funding, these teachings have flooded bookstores throughout the Muslim world and even in America, Europe, and Australia. For a case study of what they have spawned, we might look to Kosovo. Our “Islamic” schools are now filled with books published by this sect that lure the impressionable minds of our youth at an age when they are most susceptible to indoctrination. This sect of Islam, however, is not the sole source of our current crisis, and it would be wrong to place all blame on it alone; many of its adherents are peace-loving quietists, who want only to be left alone to practice their faith as they see fit. Their exclusivism is a necessary but not sufficient cause for the xenophobic hatred that leads to such violence. The terroristic Islamists are a hybrid of an exclusivist takfiri version of the above and the political Islamist ideology that has permeated much of the Arab and South Asian world for the last several decades. It is this marriage made in hell that must be understood in order to fully grasp the calamitous situation we find our community in. While the role that Western interventions and misadventures in the region have played in creating this quagmire should not be set aside, diminished, or denied, we should, however, keep in mind that Muslims have been invaded many times in the past yet never reacted like these fanatics. Historically, belligerent enemies often admired the nobility Muslims displayed in their strict adherence to history’s first humane rules of engagement that were laid down by the Prophet himself to insure that mercy was never completely divorced from the callousness of conflict.
We need to clearly see the pernicious and pervasive nature of this ideological plague and how it is responsible for the chaos and terror spreading even to the city of our Prophet, God’s peace and blessings upon him, in all its inviolability. Its most vulnerable victims are our disaffected youth who often live in desolate circumstances with little hope for their futures. Promises of paradise and easy-out strategies from the weariness of this world have enticed these suicidal youth to express their pathologies in the demonically deceptive causes of “Islamic” radicalism. The pictures they leave behind—showing the supercilious smiles on their faces, even as they hold in their hapless hands their Western-made assault rifles—are testament to the effective brainwashing taking place.
The damage being wrought is not only within Islam but also to Islam’s good name in the eyes of the world. These now daily occurrences of destructive, hate-filled violence are beginning to drown out the voices of normative Islam, thereby cultivating a real hatred in the hearts of those outside our communities. In the minds of many around the world, Islam, once considered a great world religion, is being reduced to an odious political ideology that threatens global security; that, in turn, is proving disastrous for minority Muslim communities, who now abide in increasingly hostile environments in secular societies.
What we need to counter this plague are the voices of scholars, as well as grassroots activists, who can begin to identify the real culprits behind this fanatical ideology. What we do not need are more voices that veil the problem with empty, hollow, and vacuous arguments that this militancy has little to do with religion; it has everything to do with religion: misguided, fanatical, ideological, and politicized religion. It is the religion of resentment, envy, powerlessness, and nihilism. It does, however, have nothing to do with the merciful teachings of our Prophet, God’s peace and blessings upon him. Unchecked, we will see this plague foment more such violence, until one day, God forbid, these hateful and vile adherents obtain a nuclear device, the use of which has already been sanctioned by their “scholars,” including one currently imprisoned in Saudi Arabia. If such a scenario unfolds, it is highly probable that the full wrath of Western powers will be unleashed upon a helpless Muslim world that would make even the horrendous Mongol invasions of the 13th century look like a stroll in the park.
Invariably, some will remark that a fear of Western retaliation is a sign of cowardice. For those zealots, I would recommend turning back to the Qur’an, specifically to reflect on the undeniably brave Messenger Moses, peace be upon him, who unintentionally killed an Egyptian after striking him with his powerful blow, only because he was considered an enemy, and then asked God’s forgiveness and “fled vigilantly out of fear” (28:21). This is a cautionary tale, and it behooves all of us to reflect upon it as a lesson of what not to do when oppressed, especially when we are without political authority or the means to redress our grievances. Imam al-Sahrwardi stated, “To flee from calamities is the Sunnah of Prophets.” It is best not to let our baser self, our lust for revenge, get the better of us.
We would do well to acknowledge that much of what is happening in the Muslim world and to Muslim communities in the West is from what our own hands have wrought. Muslims have been in the West for a long time and have done little to educate people here about our faith; too many of us have been occupied in our wordly affairs, while some of our mosques and schools have been breeding grounds for an ideological Islamism rather than Islam. The Qur’an clearly instructs us that when faced with calamities, we ought to look first at what we may have done to bring them upon us. Introspection is a Qur’anic injunction. Until we come to terms with this Qur’anic truth, we will remain mired in the mirage of denial, always pointing fingers in every direction but at ourselves. “Verily, God does not change the conditions of a people until they change themselves” (Qur’an, 13:11).
As Ramadan comes to a close, let us pray for the oppressed and the guidance of the oppressors, for those who have been killed, and for those who lost their loved ones, and most of all, let us heed our Prophet’s call and want mercy for everyone.